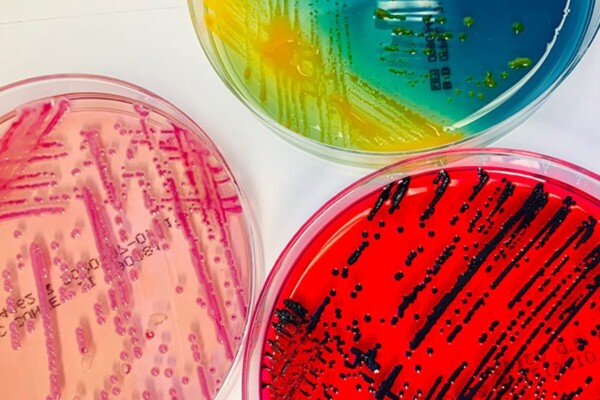
bacteria samples

A looming pandemic could be hiding in our food
August 22, 2024
Why your bathroom sink might be making you sick
August 16, 2024
35 unknown bacteria species discovered inside hospitals
January 10, 2024
When is it really necessary to take antibiotics?
December 26, 2023
Bacterial superbug cure may be hiding in your nose!
December 22, 2023